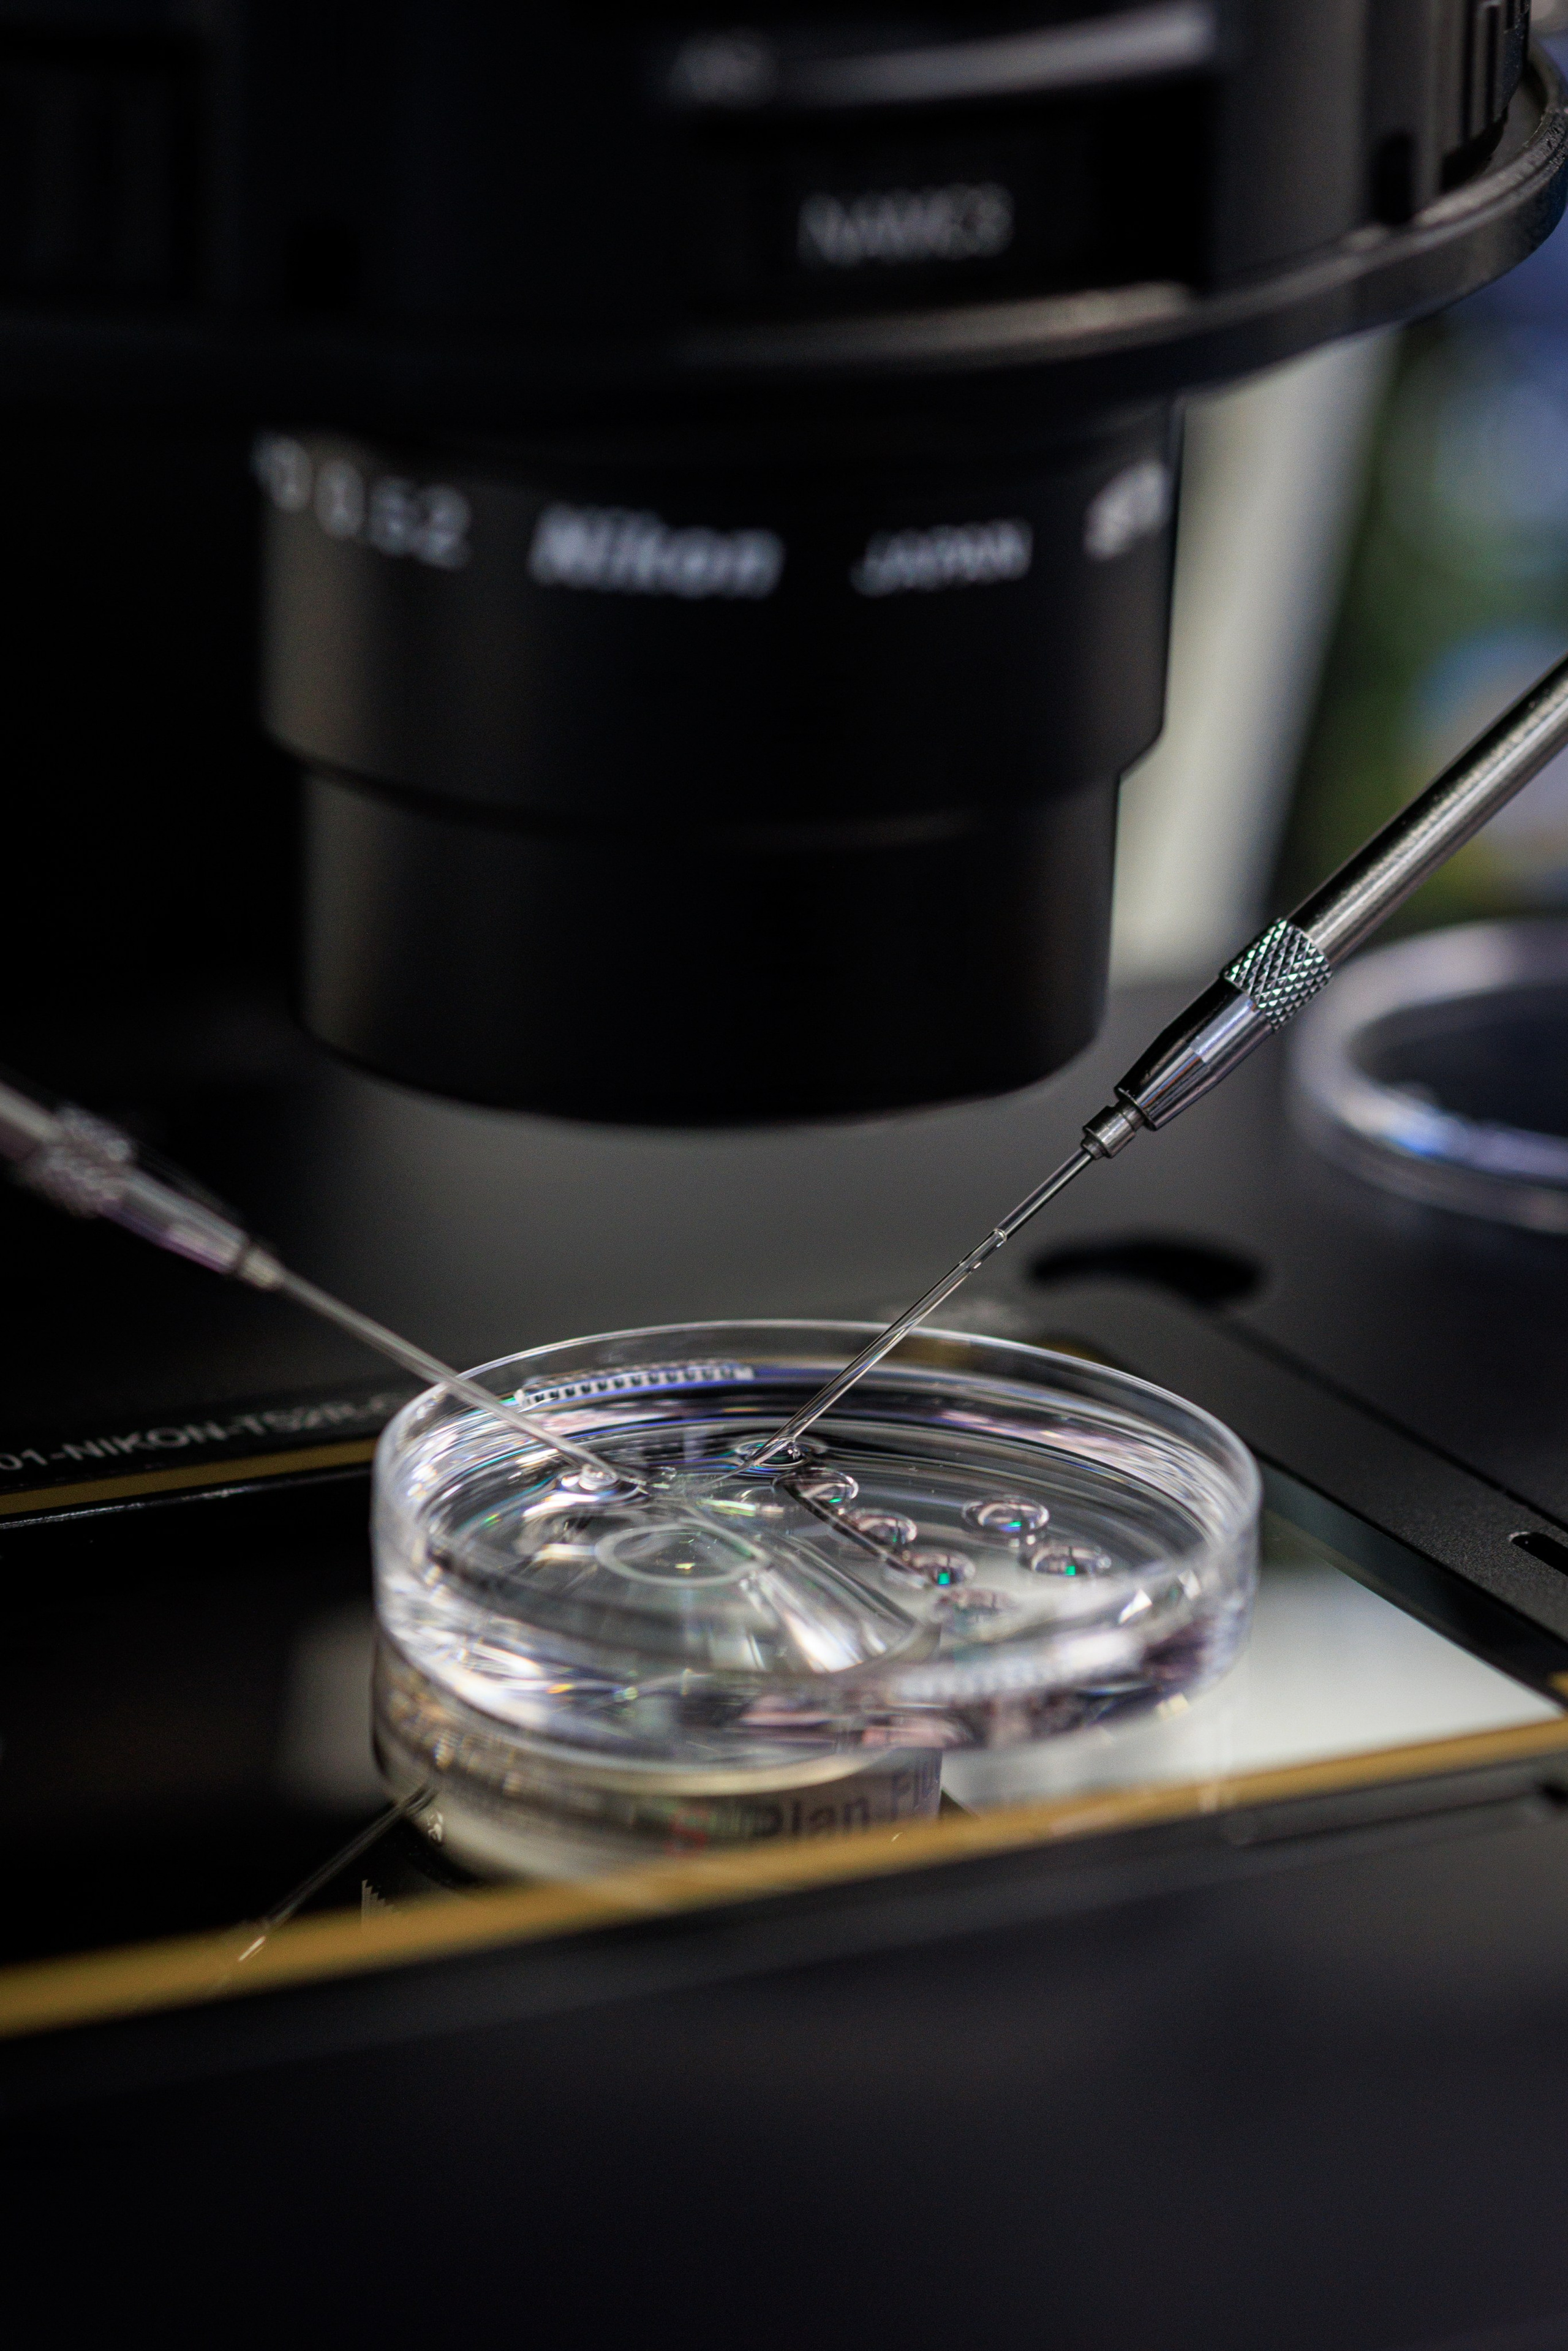
Бизнес-фотограф в Алматы — корпоративные съёмки, деловые портреты и репортажи. Профессиональный фотограф в Алматы

Работаю в жанрах бизнес-портрета, корпоративной и репортажной съёмки. За плечами — десятки съёмок для компаний, ивент-агентств и частных клиентов.
Люблю честные кадры, в которых чувствуется живое присутствие.
Мне доверяют














Более 14 лет опыта
Работаю с командами от 2 до 1000 человек
Сдача готовых фото — от 24 до 72 часов
Умею работать быстро и качественно
Никаких дополнительных оплат
Индивидуальный просчёт под задачу
Быстрое предоставление документов для бухгалтерии
Возможность заключить долгосрочный контракт
Корпоративные мероприятия
Конференции, тренинги, тимбилдинги, корпоративы
Ловлю атмосферу и ключевые моменты. Не мешаю процессу.
Lifestyle-съёмка для компаний
Для HR-бренда, соцсетей, сайта
Помогаю показать настоящих людей в работе и жизни компании.
Бизнес-портреты, командные портреты
Идеально для LinkedIn, сайта, пресс-релизов, фото для презентаций, каталога сотрудников
Снимаю в офисе, студии или на выезде. Работаю с образами.
Стоимость
Прозрачные цены без сюрпризов
Корпоративные мероприятия
Продолжительность: от 2 часов
Стоимость: от 80 000 ₸
Lifestyle-съёмка для компаний
Продолжительность: от 2 часов
Стоимость: от 70 000 ₸
Бизнес-портреты, командные портреты
Продолжительность: 1 час
Стоимость: от 35 000 ₸
— Без скрытых платежей
— Индивидуальный просчёт под задачу
— Быстрая сдача фото через облако (от 24 до 72 часов)
— Быстрое предоставление документов для бухгалтерии
— Возможность заключить долгосрочный контракт
ЗАКАЗАТЬ СЪЕМКУ